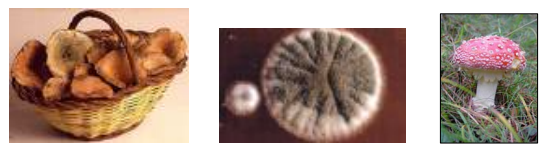
bolets

Nivells educatius:
Educació Primària, 1r cicle d’Educació Secundària
Es treballaran:
- Els fongs i els bolets com a éssers vius: el regne dels fongs, les funcions vitals (nutrició, relació i reproducció).
- Les parts d’un bolet, característiques.
- L’hàbitat i formes de vida.
- La recol·lecció de bolets .
- La identificació i classificació dels bolets més comuns que podem trobar a la zona.
- La funció dels fongs i el seu aprofitament.
Desenvolupament de l’activitat:
Presentació
- Comentari sobre els bolets i els fongs. Els alumnes exposen què saben dels bolets. Es plantegen preguntes o dubtes del tipus: de què s’alimenten, a sobre d’on viuen, què és un fong i què és un bolet, quins beneficis aporten al bosc, com saber si són comestibles, en què s’assemblen a un animal i en què a una planta, com es reprodueixen,etc.
- Breu explicació sobre com s’han de collir els bolets i perquè es fa així, quins es poden agafar i quants de cada tipus.
- Distribució de cistells.
Treball de camp
- Sortida a l’entorn proper del centre per anar a buscar bolets.
Treball a l’aula
- Tria dels bolets: separar els coneguts de la resta.
- Conversa sobre utilitats, perjudicis, funcions dels bolets i dels fongs.
- Identificació dels bolets trobats a partir de diapositives.
Treball de laboratori
- Observació de les diferents parts del bolet amb lupa binocular.
- Descripció d’un dels bolets trobats.
- Preparació de l’esporada.
- Preparació i observació microscòpica de les espores (per CS I ESO).
Observacions
El material per realitzar l’activitat el proporciona el Camp: quaderns de
presa de dades, cistell per cada grup, safates…, de totes maneres si el centre
ho creu convenient els alumnes poden portar els seus propis cistells.
Per al treball de laboratori es farà servir l’aula o el laboratori del centre. Els
instruments a utilitzar seran també els del centre (lupa binocular, càpsules de
petri, etc.). Si aquest no en disposa, serà el Camp qui els portarà.
Descarregar fitxa
Veure més activitats